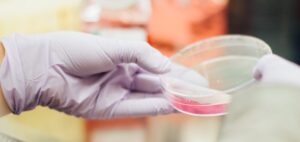

SHANK3 in Phelan-McDermid syndrome
SHANK3 is a gene that is important for the development and function of the nervous system. Genes are like instruction manuals in our bodies that
This page is your source for all of the latest news and blog posts about Phelan-McDermid syndrome (PMS).
Join the PMSF membership to receive our emails and newsletter, it is free to join.

SHANK3 is a gene that is important for the development and function of the nervous system. Genes are like instruction manuals in our bodies that

PMSF announced a research grants program in January 2023 to provide funding to highly motivated scientists studying Phelan-McDermid syndrome. Our goal is to accelerate exciting

Registration is open for our first Phelan-McDermid Caregiver Support Group. We are thrilled to invite you to register for our new Caregiver Support Groups. These groups will be a time for Phelan-McDermid syndrome caregivers to share their experience in a welcoming and supportive group setting.

What is an ICD code? An ICD code is essentially a label, or classification, that goes into a patient’s medical record. It can notate things

What was the event? PMS mom and PMSF rep Anna Williams participated at an annual Epilepsy Foundation Research Roundtable in Washington D.C. on March 24th.
A research team at Northwestern University developed a new drug and tested it in a laboratory model of Phelan-McDermid syndrome.

PMSF Releases the first in a series of Quick Resource Cards by Diane Linnehan, Director of Operations and Jenn Carter, Mom to Sloane We are

Our podcast is now available on major platforms, with a new episode posted on the 22nd of each month! by Dr. Kate Still, PhD, PMSF

by Brooke Turner Jones, Mom to Turner We are excited about the prospects of PMS Awareness Day 2023, as it will be our 5th year

Dr. Sheng-Nan Qiao at Yale University applied to study the link between brain inflammation and regression (loss of skills) in PMS. The funded project focuses on approaches for reducing neuro-inflammation when modeling Phelan-McDermid syndrome in the laboratory.

We are very pleased to announce the results of the December 2022 PMSF Board of Directors election results!

We’ve been hearing about antisense oligonucleotides (ASOs) in the news as a potential therapeutic for PMS. But what are they and how do they work?
Gaylord Rockies Resort & convention Center, 6700 N Gaylord Rockies Blvd, Aurora, CO 80019
By continuing to use this website, you consent to the use of cookies in accordance with our Cookie Policy.
Accept